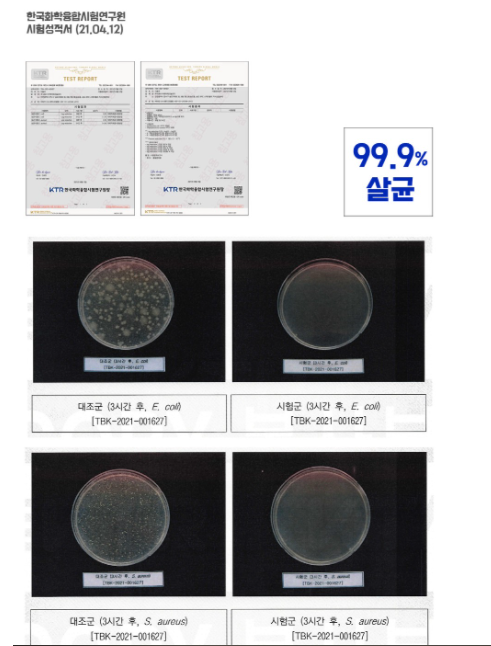

비타민 LED 스탠드 살균기, 가시광선으로 편하게 키보드 살균기
사무실 키보드는 화장실 변기 시트 보다 세균수가 많고 드럽다고 합니다. 일반세균수가 약 1.8배 높게 검출됐고(키보드: 4,900CFU/㎠, 화장실 변기시트: 2,800CFU/㎠), 병원균인 바실러스 세레우스도 키보드, 전화기, 책상 등에서 검출 된다고 합니다.
그래서 키보드 살균기를 찾아보았는데요. 키보드의 사이즈도 크고 활용성이 높은 제품을 고르기 참 힘든데, LED 비타민 살균기는 가시광선으로 UVC보다 제약이 적어 밀폐된 공간이 아니라도 키보드 살균을 하면서도 쓰기 좋고 조명효과도 기대할 수 있는 제품이였는데요.
평소 키보드 세균이 걱정 스러워 매주 세척을 하셨던 분이라면 고려해보셔도 좋을 것 같습니다. 그럼 LED 비타민 살균기는 어떤 제품인지 리뷰해보겠습니다.


집에서 컴퓨터 작업할 때 마우스와 키보드를 가장 많이 사용하게 됩니다. 손이 닿아 매번 위생에 신경을 써서 UVC 살균 램프를 많이 구매하였는데요. 마스크나 이어폰 같은 소형제품은 적당하지만, 키보드 살균기로는 비타민 LED 스탠드가 적당하였습니다. 조명효과도 고려되어 있어 멋집니다.
LED 비타민 스탠드, 키보드 살균기로 좋다!



LED 비타민 스탠드를 택배로 배송받고 패키지를 살펴보았습니다. LED 비타민 스탠드의 색상은 3가지로 지원되는 데 화이트 실버, 스페이스 블랙, 화이트브론즈 입니다. 필자는 심플한 블랙 입니다.


LED 비타민 스탠드의 매뉴얼에는 간단한 조립 방법과 궁금한 것에 대한 FAQ가 있습니다. 살균력을 위해서 9V 전압에 연결하여야 한다고 합니다. 또 제품 보증은 2년입니다.

LED 비타민 스탠드 패키지 안에는 스탠드가 있습니다. 조립을 해서 사용할 수 있게 육각모를 제공합니다.


스텐드는 쇠로 무게감이 좀 있고 튼튼하였습니다. 바닥면의 이음새에 넣어 끼워주면 됩니다.

육각모를 돌려 고정되게 되어 있는 데 나사 불리형이 아니라서 좋았습니다. 나사를 잃어버릴 필요 없이 고정되어 있습니다.

LED 비타민 스탠드의 전체 외형은 메탈 스탠드라 고급스러운 느낌을 줍니다. 또 상단에는 LED 가시광선 램프가 있어 조명효과를 줍니다.

스탠드에는 키보드 선을 통과하게 되어 있는 데 키보드 선마다 다르겠지만, 둥근 선의 고정장치로 통과가 안되었습니다. 조금 더 크면 좋을듯한데 디자인을 고려한 크기로 보여집니다.


상단에는 5개씩 4개로 20개의 촘촘한 가시광선 LED 램프가 위치하고 있습니다.
우리가 사용하는 키보드에는 세균이 많은데, 항상 살균기를 켜두면서 살균효과를 누릴 수 있습니다.


스탠드형태로 켜고 끄기 편한 장점이 있습니다. 또 조명효과를 주어 키보드를 상시 살균하면서도 멋스러움을 줍니다.

노트북 및 PC컴퓨터의 USB 포트를 이용하여서도 사용이 가능합니다. 별도의 전원이 아닌 노트북 USB로도 사용이 가능해 책상위에 두기 적당하였습니다.



비타민 LED 스탠드는 어떻게 끄나요?
상단에 터치센스가 있어 한번 눌러주면 꺼집니다. 또 눌러주면 켜지고요.
별도로 타이머가 없어 꺼지지 않고 계속 켜져 있습니다. 그래도 괜찮은 내구성을 가지고 있는데요. 1년 내내 켜놓아도 무방합니다. 10만시간 사용하실 수 있어서, 하루 8시간식 34년간은 사용하신다고 보시면 됩니다.


노트북도 상당히 키보드 사용이 많아 드러운데요. 비타민 LED 스탠드가 커서 전체를 비추기는 합니다. 하지만 노트북 면적상의 문제로 키보드 살균할 때보다는 덜 쐬여지는 느낌은 듭니다. 그렇다고 안되는 사이즈는 아닙니다.


평소 태블릿과 삼성 DEX 할 때 사용이 많은 무선 마우스와 키보드를 살균하였습니다. 또 매일 음악 들을 때 사용하는 갤럭시 버즈라이브와 무선 게이밍마우스를 살균하였습니다. 이렇게 액세서리를 살균하기 좋았습니다.
☝ 엔돌슨 TV채널 : https://tv.naver.com/v/21624202

필자는 코로나19 이슈도 있었지만 세균에 대해서 거부감이 있어 UVC 살균기를 애용하였습니다. 마스크 살균기 및 큰 통 형태의 UVC 살균 램프도 있었는데요. 키보드 전용 살균기로는 비타민 LED 스탠드가 편리했습니다. 단점이라면 UVC는 단시간에 살균이 끝나지만 가시광선을 이용하여 3시간 이상 장시간 쐬여야 한다는 점입니다.
하지만 UVC는 사람이 바라보거나 손에 쐬면 DNA가 파괴될 만큼 좋지 못하기 때문에 밀폐된 통에서 사용되는데요. 비타민 LED 스탠드는 오픈된 공간에서 편하게 사용할 수 있는 가시광선을 이용하는 만큼 조명효과와 키보드 살균에 용이하였습니다.
사용제품에 따라 장단점이 있는데, UVC(100nm~400nm)가 아닌 인체에 무해한 가시광선 파장(405nm)을 사용해 살균하기 때문에 키보드를 사용하거나 사용하지 않거나 상관없이 항상 살균을 지속할 수 있다는 점은 좋다고 봅니다.